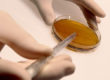

ACCUEILLIR L’AUTRE : LA FOI PLUS FORTE QUE LA PEUR
LE BON LARRON
Projection suivie d’un échange avec le frère Philippe Jaillot, o.p.
C’est l’histoire de la rencontre entre un ancien braqueur, incarcéré, et un agriculteur, visiteur de prison. Tous deux sont épris de liberté ! Vous serez touchés par le récit de leur relation « salvatrice ».
Laurence Chartier – 2016 – 26min
[rhc_start_date date_format= »dddd d MMMM 2017″ label= »DATE »]
[rhc_start_time time_format= »HH:mm » label= »HORAIRE »]
[rhc_venue_term label= »LIEU »]